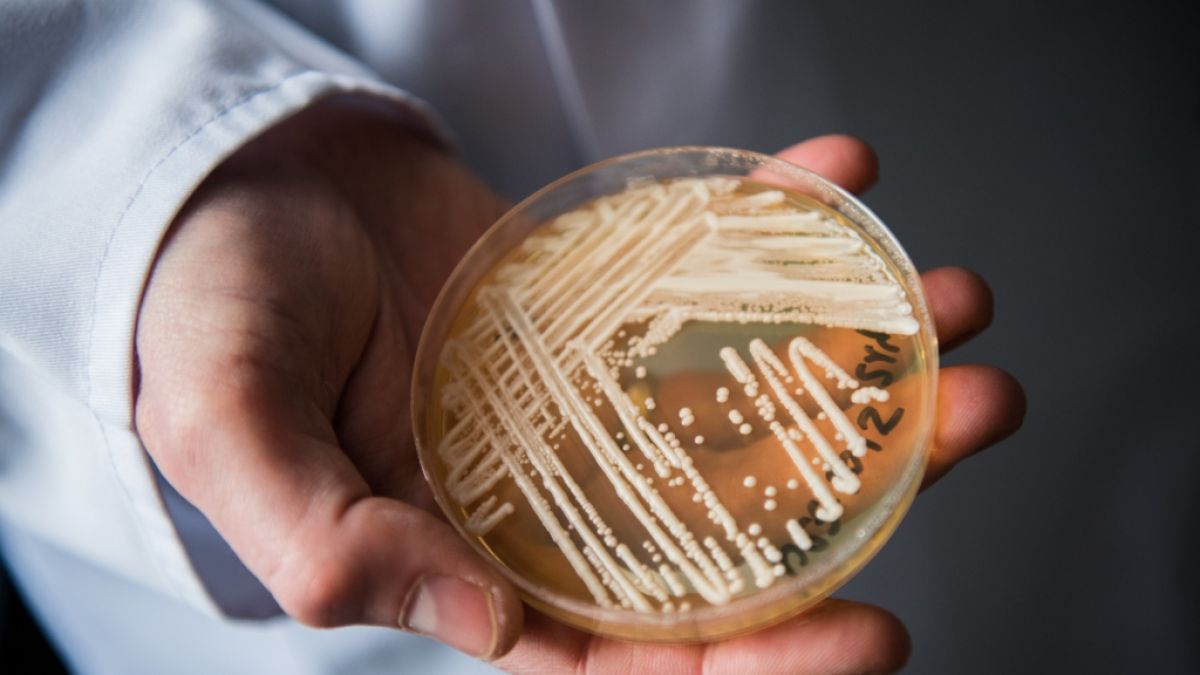
Der Leiter des Nationalen Referenzzentrums für invasive Pilzinfektionen, Oliver Kurzai, hält eine Petrischale mit dem Hefepilz Candida auris in den Händen. (Foto)

Candida auris: Tödlicher Pilz breitet sich in Deutschland aus - Experten schlagen Alarm
2009 wurde der gefährliche Pilz Candida auris erstmals nachgewiesen. Inzwischen hat sich die mitunter tödlich verlaufende Hefepilz-Infektion auch in Deutschland immer weiter ausgebreitet. Experten schlagen bereits Alarm. Das müssen Sie zu Verbreitung und Symptomen wissen.
Erstellt von Franziska Kais - Uhr
Suche
Suche
- Gefährlicher Pilz Candida auris breitet sich in Deutschland aus
- 2023 wurde der Hefepilz bundesweit 77 Mal nachgewiesen
- Candida auris resistent gegen gängige Antimykotika
- Symptome und Verbreitung der Pilzinfektion
News.de ist jetzt auch bei WhatsApp – HIER direkt ausprobieren!
Gefährlicher Pilz Candida auris breitet sich in Deutschland aus
Der erst vor wenigen Jahren entdeckte Pilz und Krankheitserreger Candida auris breitet sich rasch in Deutschland aus. 2023 sei er bundesweit 77 Mal nachgewiesen worden - das sei sechsmal häufiger gewesen als in den Vorjahren, wie aus der Auswertung des Nationalen Referenzzentrums für Invasive Pilzinfektionen (NRZMyk) mit Sitz in Jena hervorgeht. Der erst 2009 entdeckte Hefepilz ist zwischen Menschen übertragbar und gegen diverse Medikamente immun.
Experten schlagen Alarm nach Anstieg der Candida auris Fallzahlen
"Wir gehen aktuell mit hoher Sicherheit davon aus, dass es sich um einen realen Anstieg der Fallzahlen handelt und nicht um eine 'bessere Erfassung'", sagte Oliver Kurzai vom Institut für Hygiene und Mikrobiologie der Uni Würzburg, zugleich Leiter des NRZMyk, am Donnerstag (2. Mai). Bisher sei dem Referenzzentrum aber kein Todesfall in Deutschland bekannt, der direkt auf eine Infektion mit dem Hefepilz zurückzuführen ist.
Pilz Candida auris als große Gefahr für vorerkrankte oder immungeschwächte Menschen
Dennoch sei der Pilz gefährlich, gerade für vorerkrankte oder immungeschwächte Menschen. Nach Kurzais Angaben sind neben Blutstrominfektionen ("Pilzsepsis") insbesondere Infektionen von Prothesen und Fremdmaterialien im Körper durch Candida auris bedrohlich und schwer zu behandeln, etwa Infektionen von Gelenkprothesen.
Forscher dringen auf generelle Meldepflicht - hohe Dunkelziffer an Candida auris Infektionen denkbar
Den Anstieg der Fallzahlen in Deutschland hat das Forschungsteam um Alexander M. Aldejohann von der Uni Würzburg im Epidemiologischen Bulletin des Robert Koch-Instituts veröffentlicht. Nur ein Teil dieser Fälle sei im Rahmen der 2023 eingeführten Meldepflicht erfasst worden, da diese nur für bestimmte Infektionen gelte. Ein weiterer Anstieg der Fallzahlen in Deutschland müsse als wahrscheinlich angenommen werden, eine generelle Meldepflicht für jeden Labornachweis könnte eine Ausbreitung des Pilzes bremsen. Es rät zudem zu umfassenden Tests auf Candida auris.
Candida auris: Verbreitung und Symptome des gefährlichen Pilzes
So verbreitet sich der gefährliche Pilz: Gesunden Menschen setzt der Pilz gewöhnlich nicht zu. In Krankenhäusern und Pflegeeinrichtungen kann er zum Problem werden, vor allem auf Intensivstationen. Die Übertragung erfolgt über Schmierinfektionen. Durch die Luft wie etwa das Coronavirus verbreitet sich der Erreger nicht. "Gelangt Candida auris in ihren Blutkreislauf, droht eine Blutvergiftung, die in gut der Hälfte aller Fälle tödlich endet", schreiben die Forscher.
- Bei 58 von 77 im vergangenen Jahr in Deutschland registrierten Fällen waren die Patienten von dem Pilz besiedelt.
- In 13 weiteren Fällen kam es den Wissenschaftlern zufolge zu einer Infektion.
- In 6 Fällen sei der Status unklar.
- Von den besiedelten Patienten oder denen mit unklarem Infektionsstatus hätten im späteren Verlauf 5 eine invasive Infektion entwickelt.
- Die häufigsten Infektionen waren demnach Wund- und Gewebsinfektionen, Blutstrom- und katheterassoziierte Infektionen und Protheseninfekte.
So äußert sich eine Infektion mit Candida auris: Auf der Haut verursacht eine Infektion mit Candida auris zunächst nur eine Rötung. Anschließend kommt es zu einer Pilzinfektion im Blut, die schließlich verschiedene Organe wie Gehirn, Leber oder Niere betreffen und im schlimmsten Fall zu einer Blutvergiftung (Sepsis) führen kann.
Darum ist Candida auris so gefährlich: Der erst 2009 entdeckte Hefepilz Candida auris hat sich rasch international verbreitet. Von Anfang an war der überaus hartnäckige Erreger gegen einige Antimykotika - Medikamente zur Bekämpfung von Pilzbefall - und manche Desinfektionsmittel resistent.
Folgen Sie News.de schon bei Facebook, Twitter, Pinterest und YouTube? Hier finden Sie brandheiße News, aktuelle Videos und den direkten Draht zur Redaktion.
fka/hos/news.de/dpa
Erfahren Sie hier mehr über die journalistischen Standards und die Redaktion von news.de.